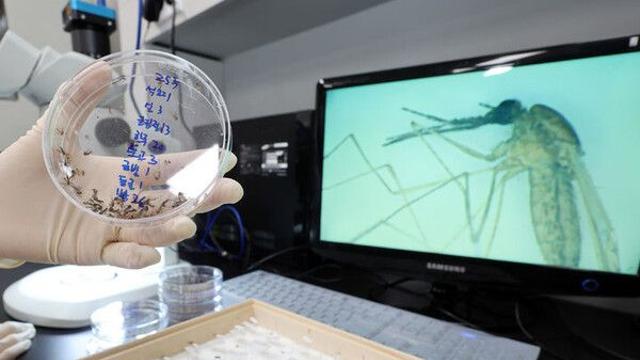
작년 말라리아 환자 94% 수도권 거주…2년 전보다 79% 증가

![[IVE ON] ꒰인가 막내 공주 졸업식에 초대합니다꒱|인기가요 이서 MC 막방 BEHIND](https://i.ytimg.com/vi/NuEdFQi6PUE/mqdefault.jpg)
[IVE ON] ꒰인가 막내 공주 졸업식에 초대합니다꒱|인기가요 이서 MC 막방 BEHIND
#IVE
2025.12.19
![[IVE ON] ꒰인가 막내 공주 졸업식에 초대합니다꒱|인기가요 이서 MC 막방 BEHIND](https://i.ytimg.com/vi/NuEdFQi6PUE/mqdefault.jpg)
#IVE
2025.12.19
![Never Ending Story - 리즈(IVE) X 김채원(LE SSERAFIM) [2025 가요대축제 글로벌 페스티벌] | KBS 251219 방송](https://i.ytimg.com/vi/PdvTyBNRwa8/mqdefault.jpg)
#IVE
2025.12.19

#박보영
2025.12.19

#IVE
2025.12.19

#강다니엘
2025.12.18

#이즈나
2025.12.18
![[라디오스타] 아이유 덕분에 저작권료 1억원 번 김태원?! '네버 엔딩 스토리' 리메이크 비하인드 공개 MBC251217방송 #라스 #김태원](https://i.ytimg.com/vi/kuNprOBu-4s/mqdefault.jpg)
#아이유
2025.12.18
![[예고편] 앤팀, 한국 데뷔의 뜨거운 맛을 보다!ㅣ만앤의 행복ㅣ&TEAM](https://i.ytimg.com/vi/IbqZpVk_97c/mqdefault.jpg)
#앤팀
2025.12.17
 |
하남시 캐릭터 굿즈 자판기 운영 시작중도일보 2025.12.06 |
 |
'영등포서 손님 커피 홀짝' 멸종위기종, 구조 8일 만에 돌연사해…무슨 일위키트리 2025.12.06 |
 |
부산시의회, 특수교육 대상 학생 예비학교 예산 증액연합뉴스 2025.12.06 |
 |
내년 1월 ‘무료 통행’ 무산…1200원→600원, 반값 할인 ‘유력해진’ 이 다리위키트리 2025.12.06 |
 |
음주 뺑소니 복역 중인 김호중, 성탄절 특사 '가석방' 심사대상에 올라위키트리 2025.12.06 |
 |
한경국립대, AI 기반 ‘진로캠프’ 운영 큰 호응중도일보 2025.12.06 |
 |
이천시, 지역 건설산업 활성화 간담회 개최중도일보 2025.12.06 |
 |
한밤중 김제 주택서 화재…80대 숨져연합뉴스 2025.12.06 |
 |
영덕 강구수협 위판시설 현대화…184억 투입연합뉴스 2025.12.06 |
 |
진주시, 화재 취약시설 대상 '겨울철 특별 안전점검'연합뉴스 2025.12.06 |
 |
올해 청주도심 모기 발생량 작년 절반 수준…"기후요인 추정"연합뉴스 2025.12.06 |
 |
영업 끝난 주점에서 난동 부린 50대, 항소심서 벌금형→집유연합뉴스 2025.12.06 |
 |
해양수산부 부산 시대…동구, 정착 지원에 총력연합뉴스 2025.12.06 |
 |
2년 전보다 비싸진 HMM…동원, 인수자금 조달 시나리오는이데일리 2025.12.06 |
![[임상 업데이트] 종근당, 퇴행성 신경질환 치료제 ‘CKD-513’ 유효성 확인](https://images-cdn.newspic.kr/thumb1/2025/12/05/7a60df04-ad07-44e5-aa06-4d3546183774.jpg) |
[임상 업데이트] 종근당, 퇴행성 신경질환 치료제 ‘CKD-513’ 유효성 확인이데일리 2025.12.06 |
 |
정상회담 한 달 만에 깜짝...무려 4.5t 싱가포르 수출 직행한 ‘이 식재료’ 정체위키트리 2025.12.06 |
 |
제천시, 충북선고속화 등 국비 2천667억원 확보…역대 최대연합뉴스 2025.12.06 |
|
작년 말라리아 환자 94% 수도권 거주…2년 전보다 79% 증가모두서치 2025.12.06 |
 |
"나도 '탈팡'하고 싶은데"…'디지털 소외' 노인들은 '끙끙'연합뉴스 2025.12.06 |
 |
대구·경북 가끔 구름 많아…낮 최고기온 5∼9도연합뉴스 2025.12.06 |